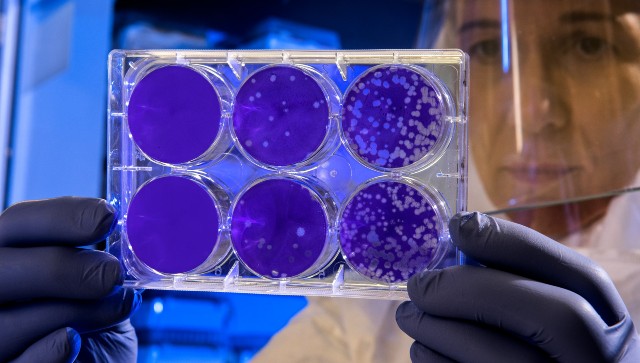
New immunotherapy for influenza virus infections may also help fight HIV and COVID-19, study suggests New immunotherapy for influenza virus infections may also help fight HIV and COVID-19, study suggests

Unlike bacterial infections, viral infections cannot be treated with antibiotics. This well-known fact is at the core of all current research into the development of antiviral drugs, including those for COVID-19 and the other viral infections that can be life-threatening, like influenza and human immunodeficiency virus (HIV). What happens often in the case of antiviral drugs is that a successful medication created for one infection also works for other viral diseases to some extent. A new study published in Nature Communications suggests that researchers based at Purdue University have devised a new type of immunotherapy that was created keeping influenza in mind but it also has the potential to be effective against COVID-19 and HIV. It’s important to note that this is not the first drug therapy developed for influenza that can also fight COVID-19, as a study in Nature in June 2020 indicated that a drug called baloxavir can help treat both viral infections. Some studies also indicate that flu shots or vaccines can offer some protection against COVID-19. Overcoming immunotherapy obstacles in treating influenza The new study in Nature Communications explains that there are three general approaches that have shown considerable efficacy in treating influenza but each of them has some limitations. The following are the three approaches listed:
- Vaccines against common influenza antigens have proved to be successful in limiting the severity and spread of the virus and are recommended to susceptible or at-risk populations annually. However, due to the rapid mutations that most viruses go through, these vaccines have to be reformulated every year and may yet be unable to combat the most virulent strains of the virus. Vaccinated patients can, therefore, contract a different strain of influenza despite getting vaccinated.
- Neuraminidase inhibitors which have been designed to block viral glycoside hydrolase enzymes are often used to create immunotherapies for influenza that are effective. Four neuraminidase inhibitors - zanamivir, oseltamivir, peramivir and laninamivir - have been approved for influenza treatment. However, these inhibitors are largely ineffective if administered more than two days after influenza symptoms appear.
- Drugs like baloxavir (as mentioned in the study above) can block the synthesis of viral mRNAs and reduce the viral load, thereby alleviating influenza symptoms. However, baloxavir-resistant strains of the influenza virus have been found in patients, indicating that the efficacy of this broad-spectrum therapy may be reduced.
The researchers, observing the limitations of existing approaches, decided to combine two potent approaches to create a potentially unbeatable solution. They selected the neuraminidase inhibitor called zanamivir which is effective against all known subtypes of influenza A and B viruses. The researchers then enhanced zanamivir’s immunogenicity by adding a potent hapten called dinitrophenyl moiety (DNP moiety) to it. This addition of a hapten can increase the production of anti-DNP antibodies against influenza and viruses. zan-DNP: A new direction in immunotherapy All humans naturally express anti-DNP antibodies to fight off viral invasions as part of a natural immune response. The zanamivir-DNP conjugate (zan-DNP) created by the researchers can not only effectively block the expression of viral enzymes but can also recruit a person’s immune system to mount a conjoined attack against the virus or virus-infected cells in the body. To test the abilities of zan-DNP, the researchers administered 0.5 micromoles/kg of zan-DNP or zanamivir plus anti-DNP antibodies to mice previously infected with a variation of influenza A virus. They found that the lung cells of the mice were successfully activated against the virus and the symptoms of the infection soon started to recede. At the same time, the uninfected lung cells of the mice were left intact and healthy to assist with recovery. The newly created zan-DNP therefore successfully launches a double-pronged attack on the virus, overcoming the obstacles of previous therapies. It is also because of these positive findings that the researchers behind this study believe that zan-DNP may also be effective against other pathogenic viral infections like COVID-19, HIV, hepatitis B and the respiratory syncytial virus (RSV). For more information, read our article on Influenza. Health articles in Firstpost are written by myUpchar.com, India’s first and biggest resource for verified medical information. At myUpchar, researchers and journalists work with doctors to bring you information on all things health.

)

)
)
)
)
)
)
)
)
